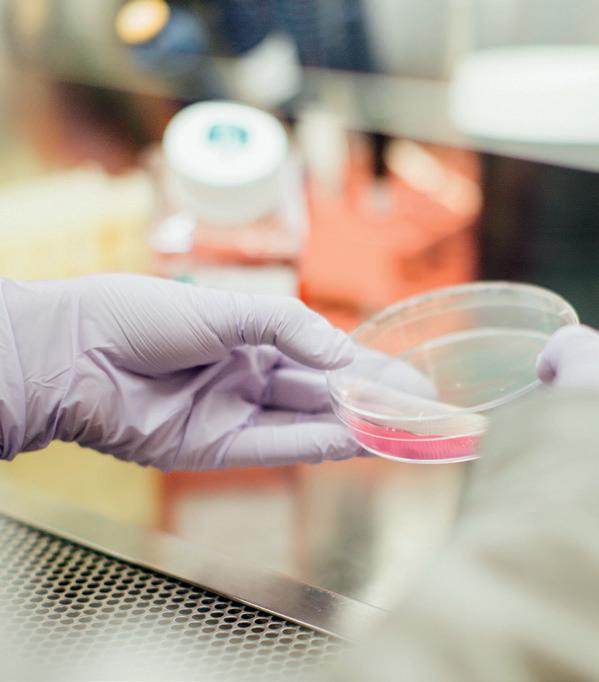

![]()


P h i l i p p i a n s 4 : 13
How are you at reading the Bible? Is it easy, hard or have you never really thought about it? Right now you are holding a copy of the Our Daily Bread Teen Edition Annual, Vol . 2 . Weâve written this for youâwherever you are at . You may know Jesus and enjoy reading the Bible . You may not . Whoever you are, we want to help you read the Bible for yourself and find out more about who exactly Jesus is .
Thereâs an article for each day of the year, and if you miss one, donât worry, no oneâs counting! We hope that through this booklet you will get to know how much Jesus loves you and wants a relationship with you . If youâve never spent time with Jesus before, then check out the What about prayer? pagesâ theyâll help you start talking with Him and sharing the stuff thatâs going on in your life with Him .
Co me and explore the Bibleâs message with usâand find out all about the God who invites You to be an important part of His family!
If you need to contact us about this booklet, or if you just want to find out a bit more about us, all our contact details are at the back of this annual!
THE OUR DAILY BREAD TEAM
READ REVELATION 21:1-7
He will wipe every tear from their eyes. There will be no more death or mourning or crying or pain (v.4).

hile I am writing this, more than 11 million Syrians have fled their homes since the start of the civil war in 2011 . Inside the country 13 .5 million people need urgent aid whole country seems to be taken over by war .
Weâre surrounded by terrible stories like this, full of pain and sadness . Itâs not hard to feel like this world is just in a complete mess . Maybe you feel like that just within your own lifeâyour mess fills your eyes with frustrated and tired tears that nobody will ever see .
But Jesus sees all our tears and offers real comfort when we hit rock bottom (2 COR. 1:3-5) . He also promises a future time where sin wonât exist anymoreâso neither will pain or sadness . In that day and in that place, âHe will wipe every tear from [our] eyes . T here will be no more death or mourning or crying or pain, for the old order of things has passed awayâ (REV. 21:4) .
All of our tears matter to God.
The God who promises freedom from tears in the future is the only One who can fully comfort us in our tears now . BC
Loving Father, thank You that our hurts and pains matter to You . T hank You for the promise of a future without tears and a life with You forever . Amen .
READ EPHESIANS 4:15,26â32
In your anger do not sin: do not let the sun go down while you are still angry (v.26).

hen I was chatting with a friend, she tol me she was fed up with someone in her family . But she didnât want to say anything to him about the way he always made fun of her she did try to talk to him, he was just sarcastic exploded in anger at him . They both just got mad at each other and the problems only ended up getting worse . I understand her situation . I handle anger the same way . I also find it hard to talk to people when they upset me . If a friend says something mean, I usually hide how I feel . When other people say unkind things, I just bury all those comments and keep my head down . But after a while, I canât help exploding . Maybe thatâs why Paul said in Ephesians 4:26: âDo not let the sun go down while you are still angryâ . Putting a time limit on our issues keeps anger in check . Instead of silently becoming bitter when someone hurts us, we can ask God to help us â[speak] the truth in loveâ (EPH. 4:15) . Got a problem with someone? Rather than hold it in, hold it up to God first . He will help us in our anger so that we can show love and forgiveness to the people who hurt us . LW
Put out the fire of anger before it blazes out of control.
Father, please guard us from uncontrolled anger . May the words that we speak please You and show love to others .
READ PHILIPPIANS
2:1-5
In humility value others above yourselves, not looking to your own interests but each of you to the interests of the others (vv.3-4).

n the first night of camp, the camp leader told everyone the plan for the week . When he finished, he asked if anyone else had anything to say . A girl stood up and asked for help told us all about her little brotherâa boy with special needsâand how he could be a challenge to care for . She talked about how tiring this was for her family, and she asked everyone there to help them keep an eye on him during the week . Her request for help came from her love and concern for her brother and her parents . As the week went on, it was great to see lots of people getting involved to support this family . Her cry for help was a reminder of how easily we can all get wrapped up in our own world and problemsâso that we donât see when others need us . Hereâs what Paul said we should do: âIn humility value others above yourselves, not looking to your own interests but each of you to the interests of the othersâ (PHIL. 2:3-4) . The next verse reminds us that this is part of living like Jesus: âHave the same mindset as Christ Jesusâ (V.5) . Caring for those in need shows Jesusâ love and concern for people who are hurting . Letâs ask God to lead us to the people who could do with our friendship today . BC
.
Nothing costs as much as caringâ except not caring.
Father, You know whoâs hurting today . Please may I have the courage to give them some of my time and attention . Please help me to say the right words .
READ EPHESIANS
5:15-21
Be very careful, then, how you liveânot as unwise but as wise, making the most of every opportunity (vv.15-16).

nterruptions are nothing new . Most days are f illed with things we didnât expect to happen Our plans are often changed by things outside of our control . Whether itâs a sudden fight with a friend, lots of unexpected homework, sickness or anything else, life can be so unpredictable . We think that these interruptions are just things that get in the way and slow us down . Have you ever thought that they could actually be Godâs way of protecting you from some unseen danger? Or that they might be opportunities to show Godâs love and forgiveness? Weâre told to make âthe most of every opportunityâ (EPH. 5:16), even the ones weâre not expecting! Whatever happens today, we can be sure God is in control . We may not know why He allows certain things to happen, but weâre still challenged to make the most of the situations we find ourselves in . Letâs be âvery carefulâ (V.15) about how we live . Rather than getting annoyed at our interruptions, we can ask God to show us what He wants us to do . And letâs remember that His plans are always better than ours!
Godâs plans never get interrupted.
Father, so often itâs the little things in life that get to me, and there seem to be so many of them . When I feel like giving up, help me to focus again on You .
READ 1 SAMUEL 24:1-10
The wisdom that comes from heaven is first of all pure; then peace-loving (Jas. 3:17).
f Kiera had done her âexperimentâ during her school science class, it might have got her top marks . Instead, she got into a lot of trouble for it . had meant to show her experiment to her teacher, but her friends talked her into testing it during lunch time . When she mixed the chemicals together inside the plastic bottle, the whole thing fizzed up and exploded! No one was hurt, but there was a lot of mess to explain . . .
Even when weâre being pressurised, thereâs always time to talk things over with God.
The Old Testament tells a story about peer pressure too . David and his friends were hiding from Saul (who was trying to kill them) in a cave (1 SAM. 24) . Saul came into the cave to try and find them, but he couldnât see them . In the darkness, Davidâs friends tried to pressurise David into killing Saul (VV.4,10) . But David didnât want to hurt him . He knew Saul was in the wrong, but he also knew that Saul was âthe Lord âs anointed [the person God had chosen to be king]â (V.6) . Our friends will sometimes want us to do things they think are a good idea . But thereâs a difference between what seems like a good idea to people and what actually pleases God (1 COR. 2:6-7) . Wisdom from God âis first of all pure, then peace-loving, considerate, submissive, full of mercyâ (JAS. 3:17) . If weâre being pressurised to do anything that doesnât match this list, then itâs probably not a good idea . When others are pushing us to do something we think might be wrong, we should make time to ask God to help us decide what to do . JBS
Thinking it over . . .
How have you been pushed into doing things in the past? Do you find it easy or difficult to say âNoâ to your friends? Whatâs the difference between pleasing people and pleasing God? (GAL. 1:10) .
READ PROVERBS 16:19-24
Clothe yourselves with compassion, kindness, humility, gentleness and patience (Col. 3:12).

cott had always wanted the kind of friendships James seemed to enjoy . So he asked him one day what made his friendships work . James replied, âYou need to be kind, even when you donât want to be!â
A friend of mine signs off many of her emails and online posts with these words: âRemember to be good to each other . â
Both those people offer great advice! The daily stresses of life can easily make us annoyed with our parents or friends . We pick at the little things that irritate us or criticise small habits that bug us . We fire out unkind words without thinking .
We must choose our words carefullyâwe donât know what damage an unkind word might cause!
The book of Proverbs gives us advice about the words we use with others . It says, âThose who guard their mouths and their tongues keep themselves from calamityâ (21:23) . And there are these warnings: âThe tongue has the power of life and deathâ (18:21); and âThe words of the reckless pierce like swords, but the tongue of the wise brings healingâ (12:18) . Jamesâ advice about being kind reminds me of Proverbs 16:24, âGracious words are a honeycomb, sweet to the soul and healing to the bones . â
Father, help us to use words that will show kindness and encouragement to others today . AC Notes
READ PHILIPPIANS
4:4â9
If anything is excellent or praiseworthyâ think about such things (v.8).
Ilove egg roti prata, a popular pancake in Singapore, my home country . So I was shocked to read that I need to run for 30 minutes to burn 240 calories . Thatâs only one egg roti prata!
Ever since I started working out in the gym, those numbers have taken on a new meaning for me . I often ask myself: Is this food worth the calories?

While itâs good to watch what we eat, itâs even more important to look at how much time we spend on social media or watching TV . Research shows that what we see can stay in our minds for a long time and change the way we act towards others . It has a âclingy effectâ, sticking to us like stubborn fat that can be so hard to lose .
If the things we do take us away from God, theyâre not worth our time.
With so many screens in front of us all day, every day, we need to make sure weâre careful about what weâre watching . That doesnât mean we should only visit Christian websites or watch Christian films; but it does mean we should always be ready to ask ourselves: Is this worth my time?
In Philippians 4:8, Paul tells us to feed our eyes and minds on âwhatever is true, whatever is noble, whatever is right, whatever is pure, whatever is lovely, whatever is admirableâ . PFC
Thinking it over . . .
Are you watching things that make your life better? Or are they drawing you away from the things that really matter?
A sk God to help you make good choices about what you spend your time doing .

Nomophobia (no-mobile-phobia): The fear of being out of mobile phone contact . Thatâs me . I love watching YouTube videos and social media feeds on my mobile . I can spend whole nights on my phone . And any free time I haveâyou guessed it; Iâm glued to the screen of my smartphone . I use my phone all the time, so much so that my nomophobia has even given me mini anxiety attacks and bruised toes . . . I got anxious when my phone was on silent mode and I couldnât find it . I bruised my toes when my foot accidentally kicked something while I was making a mad dash to the charger to plug my âdyingâ phone in . But itâs not just these physical signs that show my phone addiction . T hree more signs have showed up in my life as well:

This might sound like you if you use social media a lot . When looking through our social media feeds and coming across the latest and most exciting things happening in our friendsâ lives, a thought like this might cross our minds: âWow, she has so many pairs of nice shoes . If only I were richer, Iâm sure I can carry it off better than her .â Really, these thoughts show weâre not entirely happy in ourselves . And it might even make us spend money we donât really have so we can buy those things we want and show them off on our own social media pages . Sometimes, this is the only way we get to feel good about ourselves . But comparing ourselves to others only leads us to jealousy and envy . Our comparisons might also just get us annoyed as we throw ourselves pity parties . Proverbs 14:30 says: âA heart at peace gives life to the body, but envy rots the bones .â It âs time to stop comparing and remember that our worth is not defined by what we wear or what we have (or donât have) . We are of value in Godâs eyes just the way we are .

Time is valuable, we all know that . But letâs be honestâwe all spend a lot of time on our phones . Every thirty seconds we refresh all our social media feeds to see if there is anything new . Often, I just want to look at websites on my phone instead of spending time with God .
Truth be told, I enjoy chasing the latest news about people Iâve never met in my life and watching videos that give me nothing backâand I know Iâm not alone .
Bu t the Bible reminds us to âbe very carefulâ about how we live, âmaking the most of every opportunity, because the days are evilâ (EPH. 5:15-16) . Letâs spend our limited time in something that gives us more value . After hearing this famous quote, âOnly one life, âtwill soon be past; only whatâs done for Christ will lastâ, it struck me that I donât know when my life will end . And if my life belongs to Jesus, am I really living it for Him each day? I have since decided that one thing I will do, instead of always browsing my phone, is to set aside time to pray for my friends .

There are a few YouTubers I follow all the time, to the point that I feel as though I know them personally . I am happy when they are happy, like when they post updates that they are getting married to the love of their lives . The opposite is also true as wellâI feel down when theyâre sad .
It âs easy to get sucked in like this . We stop hanging out with people face to face because we believe the online world is enough . We can lose interest in meeting up with our friends because itâs easier and quicker to see them online . And, after all, I donât have to deal with any human conflicts if I donât come into contact with them, right? However, Iâve seen in myself, as well as in others, that when we get too attached to our phones, we start struggling to know how to talk to people face to face . We get tongue-tied and donât know how to carry on a proper conversation . Our attention span is short and we forget how to really listen to our friends and offer our support for their questions and problems .
A friend once complained to me that she had difficulty leading a church youth group because the group were too busy checking their phones and didnât hear her instructions . When it was time to break into smaller groups for discussion, they didnât talk to each other because they hadnât listened to anything sheâd said . They were glued to their phones and not paying attention .
Life is meant to be lived, not watched . So letâs start living our own lives rather than watching others live theirs .
READ JOHN 3:16â21
Everyone who does evil hates the light, and will not come into the light for fear that their deeds will be exposed (v.20).

great thinker in Ancient Greece once tried to show how selfish people can be . He told the story of a man who accidentally discovered a golden ring . One day a great earthquake opened up a mountainside and revealed the ring to the man wearing it, he also discovered that the ring made him invisible . The speaker finished the story by asking his listeners what they would do if they were the man in the story . How would they have used this invisibility?
His point was simple: if we didnât have to worry about being caught, weâd simply live however we wanted . Weâd take what we fancy and go where we want .
God sees us as we really areâand loves us!
In Johnâs retelling of Jesusâ life we find Jesus saying something similar . Jesus talked about people who try to stay under the radar to hide what theyâre doing (JOHN 3:19â20) . When we know weâre doing something wrong or selfish, rather than stopping, we just try to keep it a secret .
Jesus didnât talk about how we try to âcover-upâ our selfishness to shame us, but to offer us a better way (V.17) . He shines a light on who we really are; but rather than judge us, He offers forgiveness and Godâs love (V.16) . We donât have to be afraid of opening ourselves up to HimâHe already knows all about us . And He has already made His decision: to die on the cross in our place and pay for the stuff weâve done wrong . We can come to the light, not to show how bad we are, but how forgiving He is! MD
Notes
Our Daily Bread Ministries
No: 67/4, New No: 36, Spur Tank Rd, Chetpet Chennai 600 031, Tamil Nadu, India
P. [91] 44 2836 3435 | M. [91] 95000 37162 [91] 99626 03519 | WhatsApp: 950003 7162
Email: india@odb.org
Website: www.OurDailyBread.org
Online Store: www.DHDIndia.in
Follow us on facebook at facebook.com/ourdailybreadindia
To read our devotions online, visit odb.org or tamil-odb.org or hindi-odb.org
To download our free mobile app, visit www.ourdailybread.org/mobileapp
